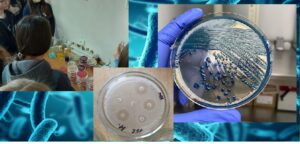

24 листопада 2025 року на кафедрі громадського здоров’я навчально-наукового медичного інституту було доцент кафедри провела тематичний майстер-клас для учасників мікробіологічного гуртка, присвячений Міжнародному тижню боротьби з антибіотикорезистентністю (World AMR Awareness Week). Здобувачі спеціальності «Громадське здоров’я» та «Медицина» ознайомилися з сучасними підходами до визначення антибіотикочутливості та опанували базові методики, що застосовуються для оцінки резистентності клінічно значущих бактерій групи ESKAPE. Особливу увагу було приділено: принципам стандартизованого визначення чутливості за EUCAST/CLSI; диско-дифузійному методу та методам визначення МІК; особливостям дослідження резистентності Staphylococcus aureus, Klebsiella pneumoniae, Pseudomonas aeruginosa, Acinetobacter baumannii та інших проблемних патогенів; ролі мікробіологічної діагностики у виборі раціональної антибіотикотерапії.
Під час практичної частини учасники мали змогу попрацювати з лабораторним матеріалом, навчитися правильно інтерпретувати антибіотикограми та обговорити реальні кейси з клінічної практики. Також була проведена коротка сесія запитань і відповідей, де здобувачі отримали додаткові роз’яснення щодо механізмів резистентності, шляхів її поширення та можливостей профілактики в умовах системи охорони здоров’я. Майстер-клас підкреслив важливість підготовки майбутніх фахівців громадського здоров’я до викликів, пов’язаних зі зростанням антибіотикорезистентності, та сприяв формуванню практичних навичок, необхідних для роботи у сфері інфекційного контролю й антимікробного нагляду.
Щиро вдячні кожному учаснику за участь та професійну зацікавленість. Разом ми можемо зупинити темпи розвитку резистентності та зберегти ефективність антибіотиків для майбутніх поколінь.